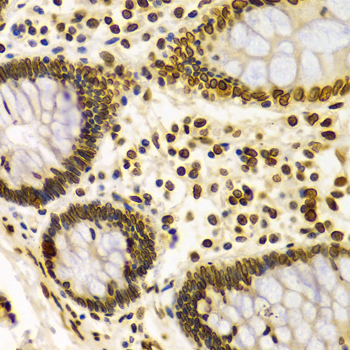

For quotations, please use our online quotation form, and you may also contact us by
service@kendallscientific.com
+1-888.733.6849 (Toll-free)
+1-617.299.7367 (Int’l))
+1-888.733.6849
Our customer service representatives are available 24 hours, Monday through Friday to assist you.| Reactivity | Human Mouse Rat |
| Tested applications | WB IHC IF |
| Recommended Dilution | WB 1:500 - 1:2000 IHC 1:50 - 1:200 IF 1:50 - 1:200 |
| Calculated MW | 65kDa |
| Observed MW | Refer to Figures |
| Immunogen | Recombinant protein of human LMNA |
| Storage Buffer | Store at -20℃. Avoid freeze / thaw cycles. Buffer: PBS with 0.02% sodium azide, 50% glycerol, pH7.3. |
| Synonym | LMNA;CDCD1;CDDC;CMD1A;CMT2B1;EMD2;FPL;FPLD;HGPS;IDC;LDP1;LFP;LGMD1B;LMN1;LMNC;PRO1 ; |

Western blot analysis of extracts of various cell lines, using LMNA antibody.

Immunohistochemistry of paraffin-embedded human breast tumor, showing staining of the nuclear envelope, using LMNA antibody.

Immunohistochemistry of paraffin-embedded rat brain using LMNA antibody at dilution of 1:200 (x400 lens).

Immunohistochemistry of paraffin-embedded human kidney cancer using LMNA antibody at dilution of 1:200 (x400 lens).

Immunohistochemistry of paraffin-embedded mouse brain using LMNA antibody at dilution of 1:200 (x400 lens).

Immunohistochemistry of paraffin-embedded mouse kidney using LMNA antibody at dilution of 1:200 (x400 lens).
Immunohistochemistry of paraffin-embedded Human colon using LMNA antibody at dilution of 1:100 (x400 lens).

Immunohistochemistry of paraffin-embedded Human esophageal using LMNA antibody at dilution of 1:100 (x400 lens).

Immunohistochemistry of paraffin-embedded human esophageal cancer using LMNA antibody at dilution of 1:100 (x400 lens).

Immunohistochemistry of paraffin-embedded Human gastric using LMNA antibody at dilution of 1:100 (x400 lens).

Immunohistochemistry of paraffin-embedded Human gastric cancer using LMNA antibody at dilution of 1:100 (x400 lens).

Immunohistochemistry of paraffin-embedded Human kidney using LMNA antibody at dilution of 1:100 (x400 lens).

Immunohistochemistry of paraffin-embedded Human kidney cancer using LMNA antibody at dilution of 1:100 (x400 lens).

Immunohistochemistry of paraffin-embedded Human liver injury using LMNA antibody at dilution of 1:100 (x400 lens).

Immunohistochemistry of paraffin-embedded liver cancer using LMNA antibody at dilution of 1:100 (x400 lens).

Immunohistochemistry of paraffin-embedded Rat heart using LMNA antibody at dilution of 1:100 (x400 lens).

Immunofluorescence analysis of HeLa cell using LMNA antibody. Blue: DAPI for nuclear staining.

Immunofluorescence analysis of U2OS cell using LMNA antibody.
Lamins are nuclear membrane structural components that are important in maintaining normal cell functions such as cell cycle control, DNA replication, and chromatin organization (1-3). Lamin A/C is cleaved by caspase-6 and serves as a marker for caspase-6 activation. During apoptosis, lamin A/C is specifically cleaved into a large (41-50 kDa) and a small (28 kDa) fragment (3,4). The cleavage of lamins results in nuclear disregulation and cell death (5,6).
N/A